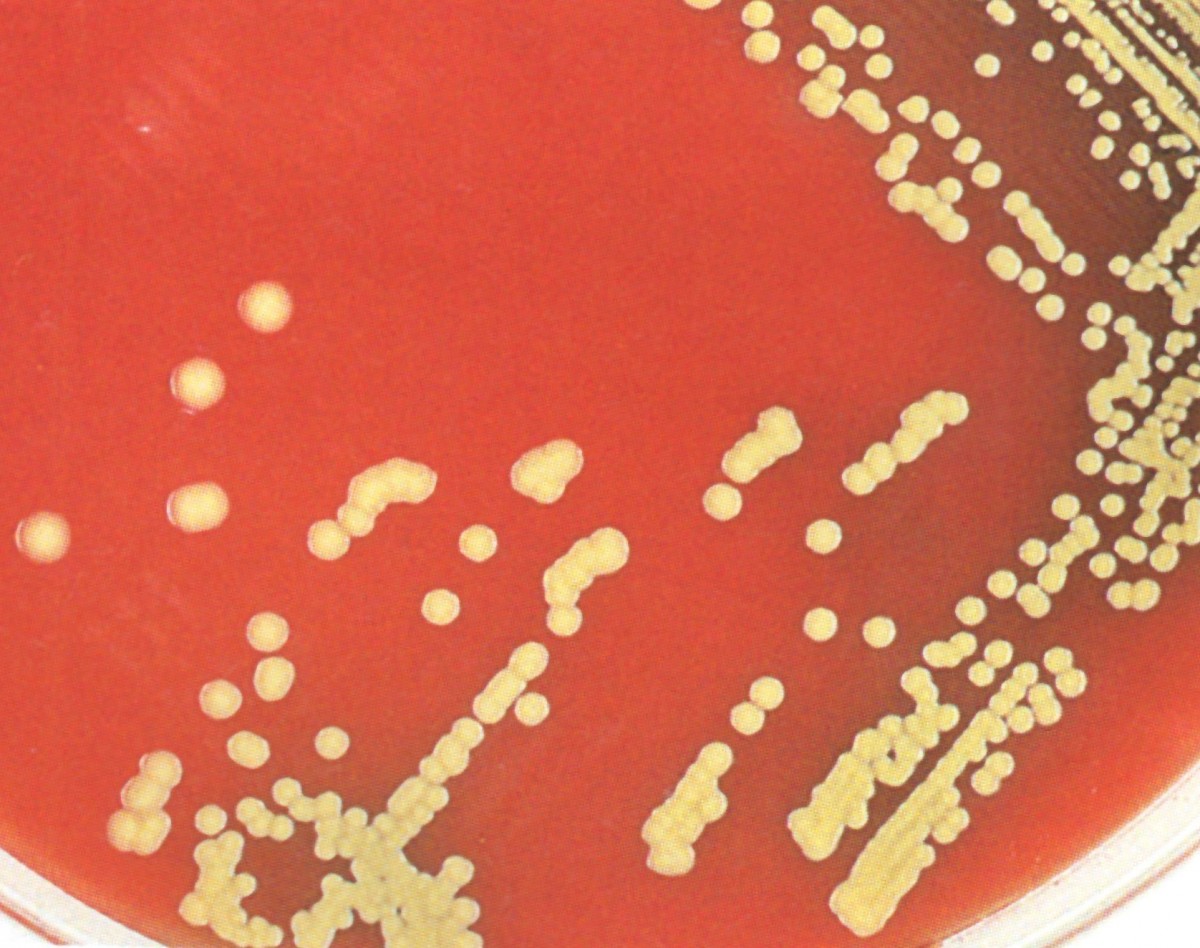
وبینار ارتباط بین تغذیه ومیکروبیوم درایام عیدنوروز

وبینار ارتباط بین تغذیه ومیکروبیوم درایام عیدنوروز
برگزار شده
وبینار ارتباط بین تغذیه ومیکروبیوم درایام عیدنوروز
برگزار شده
توضیحات
دراین وبینارموضوعات زیربررسی میشود:
چه غذاهایی درایام عیدنوروزبخوریم
چه طورمیکروبیوم خودراسالم نگه داریم
ارتباط بین میکروبیوم وتغذیه چگونه است
میوه وسبزیجات چه تاثیری درمیکروبیوم بدن انسان دارند










